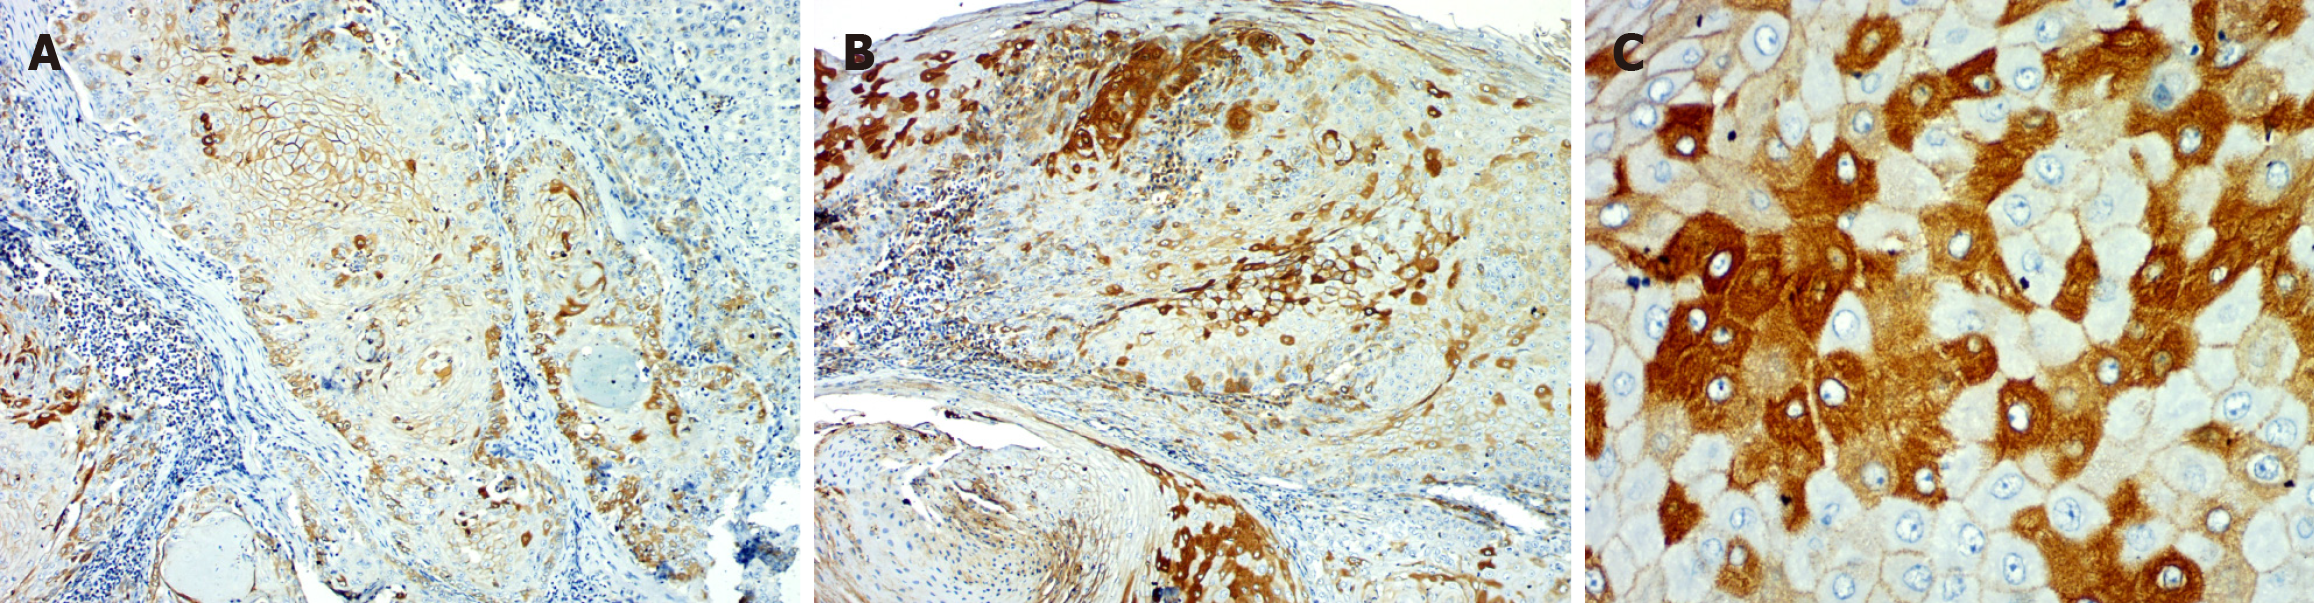
Figure 2

Published online Dec 20, 2025. doi: 10.5493/wjem.v15.i4.110372
Revised: June 21, 2025
Accepted: September 5, 2025
Published online: December 20, 2025
Processing time: 197 Days and 17.2 Hours
Oral squamous cell carcinoma (OSCC) is a frequent cancer affecting the oral cavity. OSCC is usually preceded by occurrence of precursor lesions, which de
To evaluate the role of E-cadherin and ZEB1 in oral leukoplakia and OSCC.
A total of 60 cases i.e., oral leukoplakia/oral epithelial dysplasia (OED) (n = 30) and OSCC (n = 30) were included. Immunohistochemistry was performed utilizing two markers: E-cadherin and ZEB1. The Mann-Whitney U test was em
Reduction in the expression E-cadherin and altered localization were noted from OED to OSCC. Overexpression of ZEB1 along with cytoplasmic accumulation was noted in OED, with marked expression in OSCC. ZEB1 epithelium intensity and ZEB1 connective tissue percentage contributed to the discriminant function with an accuracy of 85% for the classification of OED from OSCC.
Loss of E-cadherin and up-regulation of ZEB1 from OED to OSCC, predisposes to induction of epithelial-mesen
Core Tip: The study demonstrates the presence of the epithelial-mesenchymal transition (EMT) phenomenon in oral premalignant and malignant lesions suggesting it to be an early change in carcinogenesis. The loss of E-cadherin and up-regulation of zinc-finger E-box-binding homeobox 1 from oral epithelial dysplasia to oral squamous cell carcinoma cor
- Citation: Panchannavar GS, Angadi PV. Immunohistochemical expression of epithelial mesenchymal transition proteins ZEB1 and E-cadherin in oral leukoplakia and oral squamous cell carcinoma. World J Exp Med 2025; 15(4): 110372
- URL: https://www.wjgnet.com/2220-315x/full/v15/i4/110372.htm
- DOI: https://dx.doi.org/10.5493/wjem.v15.i4.110372
Oral squamous cell carcinoma (OSCC) accounts for the greatest frequency among all the oral cavity cancers, amounting to 2%-4%, and is the 2nd most common cancer in India[1,2]. It is characterized by a substantial level of local aggressiveness, invasion, and regional lymph node involvement, as well as a high fatality rate[1,2]. In South Asian countries, the use of smokeless tobacco and areca nut chewing remain the chief risk factors associated with OSCC[3]. Regardless of significant advances in treatment, the 5-year overall survival is less than 50%, and management is associated with severe functional and cosmetic defects associated with substantial morbidity[2].
OSCC is usually preceded by the occurrence of potentially malignant lesions, which demonstrate a varying degree of malignant transformation potential[3]. Timely identification and treatment of potentially malignant lesions is essential to improve patient quality of life and prolong survival duration[4]. Oral leukoplakia is a potentially malignant disorder of the oral mucosa[5]. The histological characteristics of oral leukoplakia manifest as varying degrees of oral epithelial dysplasia (OED) and cancer[6]. OED reflects histological changes characterized by the loss of uniformity or of the ar
The multi-step process of cancer growth is marked by the accumulation of genetic flaws and mutations that are re
A key step in EMT is the loss of E-cadherin, an essential “cell adhesion molecule” that maintains epithelial integrity[10,11]. E-cadherin repression has been linked to enhanced tumor migration and invasion[10]. Many transcription factors influence E-cadherin expression, including ZEB1/2, SIP1, SNAIL, SNUG, and TWIST[10,11]. These molecules bind to the E-box domain, thus inhibiting E-cadherin[11].
ZEB1 is a “transcription factor” that belongs to the zinc finger E-box binding homeobox family. This molecule enhances tumor invasion and metastasis by activating EMT[12-14]. The regulation of target genes through its protein-binding domains, particularly that of E-cadherin, is one of the ways ZEB1 promotes EMT[13-15]. Thus, ZEB1 plays a crucial part in E-cadherin down-regulation[16]. Many human cancers, including uterine cancer, pancreatic cancer, osteosarcoma, lung cancer, breast cancer, etc., exhibit aberrant ZEB1 expression[16].
E-cadherin downregulation and overexpression of ZEB1 have been reported in several cancers, including colorectal carcinoma, lung carcinoma, esophageal carcinoma, breast carcinoma, etc.[16]. This has been associated with poorer prognosis in terms of decreased survival rates and regional as well as distant metastasis[16]. Currently, there are just a few studies examining the clinical importance or link between ZEB1 and E-cadherin in OSCC, and no research has been conducted on potentially malignant disorders of the oral cavity. Thus, the present study aimed to evaluate the expression and correlation of EMT markers E-cadherin and ZEB1 in OED and OSCC.
Following institutional ethics committee permission, 60 paraffin-embedded tissue blocks of clinically and histologically confirmed cases of OSCC and OED were taken from the department’s archives for the retrospective investigation. The study was reviewed and approved by the Karanataka Lingayat Education, Vishwanath Katti, Institute of Dental Sceinecs Institutional Review Board, approval No. 1321.
From each block, three 4 μm tissue slices were cut and placed onto slides coated with “aminopropyltriethoxysilane”. Hematoxylin and eosin were used to stain one slide, and anti-ZEB1 antibody (1:100 Thermo Fischer Scientific United States) and anti-E-cadherin antibody (pre-diluted PathnSitu) were used to stain the remaining slides immunohistochemically. The PolyExcel HRP/DAB Detection System Two-Step Universal Kit (PathnSitu Catalogue no. #PEH002/ United States) was used for visualization.
The clinical data for the cases was gathered and organized from the archival registers. The Hematoxylin and eosin-stained slides of OED slides were graded as per the World Health Organization 2017 classification, and OSCC cases were classified according to Bryne’s classification. “Intensity (mild, intense), localization (membrane, cytoplasm, nuclear), and percentage of staining positivity (0: Absent, 1: 1%-25%, 2: 25%-50%, 3: > 50%)” were the three primary criteria used to examine all of the slides. For E-cadherin, the evaluation was only in the epithelium. Since ZEB1 expression was in both epithelium and connective tissue, the evaluation was done in both the tissues. Controls for the immunohistochemical staining in each batch were used as per the manufacturer’s instructions, i.e., normal oral epithelium for E-cadherin and high-grade ductal carcinoma of the breast for ZEB1.
The Mann-Whitney U test was used to evaluate the variations in ZEB1 and E-cadherin expression among the study groups. The relationship between ZEB1 immuno-expression and E-cadherin was evaluated using Spearman correlation. Univariate analysis for difference in expression of E-cadherin and ZEB1 in OED and OSCC was assessed using the χ2 test. Discriminant functional analysis for discriminations of two groups (OED and OSCC) was done, and classification acc
Intensity: In OED, 15 cases had mild staining, while 15 cases demonstrated strong staining. In OSCC, 10 cases showed mild and 19 cases showed intense staining. E-cadherin intensity was almost similar in OSCC and OED (P = 0.4420).
Location: OED cases showed E-cadherin expression predominantly located in the membrane (n = 24). In OSCC, most of the cases showed membranous with cytoplasmic location (n = 25). A statistically significant change of location from membranous to cytoplasm in OSCC as compared to OED was evident (P = 0.0001).
Percentage: In the OED, the majority of cases (n = 24) exhibited over 50% positivity for E-cadherin, whereas in OSCC, 15 cases shown over 50%, 9 instances displayed 25%-50%, and 5 cases indicated 1%-25% positivity. There was a significant reduction in the percentage of positivity of E-cadherin expression in OSCC as compared to OED (P = 0.0315) (Table 1, Figures 1 and 2).
Intensity: In the OED, 21 cases exhibited mild expression, whereas 9 cases demonstrated severe intensity. Eleven cases of OSCC had intense ZEB1 staining in the epithelium, while 19 cases had mild staining. There was no statistically significant difference noted (P = 0.6627).
Location: OED to OSCC showed a change in site from nuclear to mostly cytoplasmic expression, however this change was not statistically significant (P value = 0.773).
Percentage: Eighteen OED cases had > 50% ZEB 1 positivity in the epithelium, ten had 25%-50% positivity, and two had 1%-25%. In OSCC, the majority of the cases (n = 23) showed > 50%, 6 cases 25%-50%, and 1 case 1%-25% positivity. Overall, the percentage of positivity from OED to OSCC increased significantly in both groups (Table 2, Figures 1 and 3).
| ZEB1 expression | Intensity | Location | Percentage of positivity | ||||||||||||
| 0 | 1 | 2 | Value | 0 | 1 | 2 | 3 | 4 | Value | 0 | 1 | 2 | 3 | Value | |
| OED (n = 30) | 0 | 21 | 9 | - | 0 | 0 | 22 | 4 | 4 | - | 0 | 2 | 10 | 18 | - |
| OSCC (n = 30) | 0 | 19 | 11 | P = 0.6627 | 0 | 0 | 30 | 0 | 0 | P = 0.7730 | 0 | 1 | 6 | 23 | P = 0.2643 |
Intensity: The majority of cases (n = 28) in OED showed intense staining. However, in OSCC, only 11 cases showed intense staining, while the rest (n = 18) showed mild expression. A progressive reduction in intensity of stromal expression from OED to OSCC was evident (P = 0.0038).
Percentage: Twenty-three OED instances had > 50% positivity, six had 25%-50% positivity, and one had 1%-25%. However, in OSCC, the majority (20 cases) had decreased expression (1%-25% positive), while only 5 cases had > 50% and 4 cases had 25%-50%. A significant difference in the percentage of positivity was seen, with maximum stromal expression observed in OED and a marked reduction seen in OSCC (P = 0.0001) (Table 3, Figure 3).
Regarding the intensity of expression in both groups, a significant positive correlation (r = 0.2195) was found (P = 0.0376); that is, an increase or decrease in E-cadherin intensity was correlated with an associated increase or decrease in ZEB1 intensity. E-cadherin membrane expression and ZEB1 cytoplasmic localization were shown to be negatively correlated (r = -0.1861), indicating that the two markers have an inverse connection with regard to their cellular localization. There was an adverse relationship (r = -0.0751) between the percentage of positivity for ZEB1 and E-cadherin; that is, when the percentage of positivity for E-cadherin decreased, ZEB1 expression increased.
Five of the eight factors that were examined indicated a significant difference between the OSCC and OED groups. ZEB1 epithelial location (mostly cytoplasmic expression was noted in OSCC as compared to nuclear and cytoplasmic expression in OED), ZEB1 connective tissue intensity (intense expression in OED as compared to OSCC), ZEB1 CT percentage (increased expression in OED as compared to OSCC), and E-cadherin location (cytoplasmic location in OSCC as compared with membranous expression in OED) were all significantly different between the OED and OSCC groups (χ2 test, Table 4).
| Variables | OED | % | OSCC | % | Total | % | χ2 | P value |
| E-Cad intensity | 18 | 60.00 | 19 | 63.33 | 37 | 61.67 | 0.0710 | 0.7910 |
| E-Cad location | 8 | 26.67 | 25 | 83.33 | 33 | 55.00 | 19.4610 | 0.0001b |
| E-Cad percentage | 25 | 83.33 | 15 | 50.00 | 40 | 66.67 | 7.5000 | 0.0060b |
| ZEB1 EPI intensity | 9 | 30.00 | 11 | 36.67 | 20 | 33.33 | 0.3000 | 0.5840 |
| ZEB1 EPI location | 8 | 26.67 | 1 | 3.33 | 9 | 15.00 | 9.2310 | 0.0020b |
| ZEB1 EPI percentage | 18 | 60.00 | 23 | 76.67 | 41 | 68.33 | 1.9260 | 0.1650 |
| ZEB1 CT intensity | 28 | 93.33 | 15 | 50.00 | 43 | 71.67 | 13.8710 | 0.0001b |
| ZEB1 CT percentage | 23 | 76.67 | 6 | 20.00 | 29 | 48.33 | 19.2880 | 0.0001b |
Considering that several variables showed differences in the two groups, a stepwise discriminant analysis was planned to study the efficacy of these variables for classification of the cases in OED and OSCC. Only 3 variables entered into the analysis, i.e., E-cadherin location, ZEB1 CT intensity, and ZEB1 CT percentage represented the best discriminators (Table 5). The classification matrix demonstrated 85% accuracy in correctly classifying a case as either OED or OSCC based on these three parameters (Table 6).
| Variables | Wilks’ Lambda | Partial Lambda | F-remove (1, 56) | P level |
| E-cadherin location | 0.5762 | 0.7532 | 18.3489 | 0.0001a |
| ZEB1 CT intensity | 0.5607 | 0.7740 | 16.3487 | 0.0002a |
| ZEB1 CT intensity | 0.4894 | 0.8869 | 7.1442 | 0.0098a |
| Step 3, N of vars in model: 3; grouping: Groups (2 groups) | ||||
| Wilks’ Lambda: 0.43402 approx. F (3, 56) = 24.342 P < 0.0000 | ||||
| Variables | Un-standardized coefficients | Standardized coefficients | Sectioning points | |
| E-cadherin location | -1.5935 | -0.6628 | -1.1228 | 1.1228 |
| ZEB1 CT intensity | 1.5171 | 0.6352 | - | |
| ZEB1 CT intensity | 1.1142 | 0.4478 | - | |
| Constant | -0.6553 | - | - | |
| Eigen value | 1.3040 | 1.3040 | - | |
| Predicted classifications | Observed classifications | ||
| Percentage | OED group | OSCC group | |
| OED group | 86.7 | 26 | 4 |
| OSCC group | 83.3 | 5 | 25 |
| Total | 85.0 | 31 | 29 |
ZEB1 epithelial percentage and ZEB1 connective tissue intensity were the only two parameters that showed a significant association with lymph node metastasis in OSCC in this study.
EMT is a crucial molecular process that plays a vital role in OSCC progression (EMT)[16,17]. This is a complex process in which epithelial cells relinquish most of their morphological characters while obtaining mesenchymal characteristics[17]. EMT is known to be induced by numerous markers, viz., epithelial markers, mesenchymal markers, and transcription factors[18,19]. Epithelial markers are E-cadherin, occludin, claudins, plakoglobin, desmoplakin, desmoglein, and cytokeratins, and reduction of these markers is noted in EMT[17]. Mesenchymal markers include N-cadherin, fibronectin, alpha-smooth muscle actin, vimentin, and matrix metalloproteinases, and these are known to be overexpressed in EMT[18]. Various transcription factors are also involved, such as TWIST1/2, SNAIL1/2, ZEB1/2, and SLUG. Among all these markers, E-cadherin is the best known and most reliable marker in EMT[18,19]. Reduction in its expression is considered the earliest change suggesting loss of epithelial phenotype. It is influenced by various transcription factors[18,19]. ZEB1 is the master transcription regulator factor that has been associated with most of the signaling pathways, including the Wnt pathway, phosphatidylinositol 3-kinase/protein kiinase B pathway, transforming growth factor β, Rat sarcoma virus/extracellular signal-regulated kinase, and nuclear factor kappa B pathway in the process of EMT[18-28]. ZEB1 and E-cadherin are interdependent on each other in the process of EMT. Thus, using immunohistochemistry, the current study sought to assess the expression and association of the EMT markers ZEB1 and E-cadherin in OED and OSCC.
The OED group observed a decrease in intensity and positive% from mild to moderate to severe dysplasia. A switch in location of E-cadherin from membrane to cytoplasmic expression was noted, which was consistent with previous research[29-31]. In advanced OED, the loss of cell adhesion mediated by E-cadherin is correlated to the loss of epithelial architecture[29-31]. Its participation in beta-catenin activation and nuclear translocation could explain its change from membrane to cytoplasmic expression. This will activate signaling pathways such as the Wnt pathway, which will enhance the malignant potential in OED[29-31].
In OSCC, there was a considerable decrease in intensity and proportion of positivity and a shift from membrane to cytoplasmic location consistent with findings from literature[32]. Loss of differentiation and higher grades presented a decrease in E-cadherin expression, which is in line with histological observations of epithelial phenotypic loss. Reduced E-cadherin expression is therefore crucial for the change of OED to OSCC[32]. In OSCC, changes in E-cadherin expression are related to the development of an invasive phenotype and a poor clinical outcome[33].
E-cadherin membrane loss and cytoplasmic translocation occur when the E-cadherin beta-catenin complex is disrupted[33]. Thus, there is increased cytoplasmic free beta-catenin that forms a multi-protein degradation complex with “serine/threonine kinases casein kinase 1 and glycogen synthase kinase 3 beta (GSK3), the adenomatous polyposis coli protein, and the scaffold protein axin”[33,34]. Beta-catenin is directed for proteasomal breakdown by GSK3 after casein kinase 1 phosphorylates N-terminal serine/threonine residues[33,34]. Following Wnt particle attachment to serpentine frizzled receptors, a signaling cascade is initiated, and low-density lipoprotein receptor-related protein 5 and 6 co-receptors send signals to the cytoplasm by blocking GSK3[33,34]. As a result, cytoplasmic catenin escapes degradation and collects within the cytoplasm before translocating to the nucleus, activating the Wnt signaling pathway[33,34].
The intensity and percentage of ZEB1 positivity increased in OED epithelium with the increase in grade of dysplasia. This finding is similar to the research done by Ahmed et al[35] in 2017. The expression of ZEB1 was in the basal layer in moderate and severe dysplasia, as well as some cytosolic expression in the spinous layer. The most plausible explanation for such an increase in expression and shift into the cytoplasm is its function in activating target genes involved in gaining the mesenchymal phenotype and promoting malignant transformation.
In OSCC, ZEB1 expression exhibited higher intensity and percentage of positive cells as well as predominant cytoplasmic expression. ZEB1 switches from a predominantly nuclear subcellular site in dysplasia to a heavily cytosolic subcellular location in cancer. Experiments have shown that phosphorylation of ZEB1 by particular kinase pathways causes cytosolic localization[35,36]. Changes in the cancer cells' surrounding environment may be causing this alteration in signaling. ZEB-1 activates mesenchymal differentiation target genes via interacting with the acetyltransferases p300/p300/CBP-associated factor and SMADs[36]. Increased ZEB-1 expression is associated with a worse overall survival rate and recurrence in colorectal, esophageal squamous cell, pancreatic, gastric, and hepatocellular cancers[35]. According to Ahmed et al[35], the presence of ZEB1 in the cytosol of certain cells indicates a molecular mechanism for subcellular distribution regulation. SNAIL and TWIST, two functionally related EMT-transcription factors, are regulated in part by phosphorylation, which affects nuclear localization directly[36].
The increase in the percentage of positivity of ZEB1 expression in OSCC was consistent with various studies reported in the literature[36]. The probable reason for enhanced expression of ZEB1 could be attributed to aberrant activation of EMT, thereby causing relocation and elevated accumulation of ZEB1 in the cytoplasm.
ZEB1 expression in the stroma is analogous to that of immune cells and/or a specific subgroup of fibroblasts. In comparison to OSCC, ZEB1 stromal expression was greater in OED in terms of both intensity and positive percentage. It is unknown what the real cause or process is. The most plausible theory is that it controls the differentiation of stromal fibroblasts. ZEB1 in stromal carcinoma-associated fibroblasts (CAFs), leads to enhanced production and secretion of several paracrine signaling molecules into the surrounding stroma, such as fibroblast growth factor 2, fibroblast growth factor 7, vascular endothelial growth factor A, and interleukin 6.
It has been demonstrated that these paracrine signaling molecules, which are produced from stromal CAFs, bind to certain receptors on the tumor epithelial cells and activate p53, resulting in increased tumor growth and accelerated metastatic development in a variety of cancer types. Therefore, the ZEB1/p53 axis is a crucial stroma-specific signaling route that predisposes to carcinogenesis, and ZEB1 may act as an upstream regulator of p53 in stromal CAF.
The stromal cells with ZEB1 positivity have been reported in colon, bladder, breast, and lung carcinomas[37,38]. It has been hypothesized that ZEB1-dependent paracrine signaling from the stroma may influence E-cadherin regulation in tumor regions. Moreover, ZEB1 may predispose to EMT-associated carcinogenesis due to its role as a transcriptional repressor that negatively regulates E-cadherin expression, as evidenced in OSCC[38,39]. The existence of ZEB1-positive stromal cells implies that ZEB1 is significantly involved in carcinogenesis; nevertheless, the exact mechanism underlying ZEB1 expression in the stroma remains undisclosed.
The upregulation of ZEB1 and the diminished expression of E-cadherin indicate that the loss of E-cadherin may lead to a reduction in cell-cell adhesion, which is the preliminary event in EMT. The expression of E-cadherin is controlled at several levels, as demonstrated in different types of cancer. “ZEB1, ZEB2, SNAI1 (SNAIL), SNAI2 (SLUG), E12/E47, and TWIST1/2” are examples of nuclear factors or “E-cadherin transcriptional repressors” that limit E-cadherin transcription[39].
EMT has been linked to a higher incidence of both local and distant metastases in a number of malignancies[40]. ZEB1 epithelial percentage and ZEB1 connective tissue intensity were the only two parameters that showed a significant association with lymph node metastasis in OSCC in this study. ZEB1 thus inhibits E-cadherin expression, predisposing to the development of metastasis via direct as well as micro-environmental signals.
In the current study, discriminant function analysis was performed to describe the clinical relevance of the EMT markers expression. The main discriminators for OED and OSCC, according to the stepwise analysis, were E-cadherin location, ZEB1 CT intensity, and ZEB1 CT percentage, which were used to generate a discriminant function. Based on this, the protein expression of the new case can be added into the equation, and the discriminant function established can confidently categorize it into either OSCC or OED with 85% accuracy. It can also be used to predict the malignant potential in OED. No discriminant functions have been previously reported using these two markers.
The present study has shown the presence of the EMT phenomenon in oral premalignant and malignant lesions, which suggests that EMT is an early change and can predispose to carcinogenesis. The study showed loss of E-cadherin and up-regulation of ZEB1 from OED to OSCC, corresponding to its role in induction of EMT and correlated to regional lymph node metastasis, thus promoting tumor progression, invasion, and metastasis. Discriminant formulas have been established to ascertain the malignant potential and classify instances of OED and OSCC based on EMT marker expression, specifically E-cadherin localization, ZEB1 connective tissue intensity, and ZEB1 connective tissue percentage, achieving 85% accuracy.
| 1. | Sung H, Ferlay J, Siegel RL, Laversanne M, Soerjomataram I, Jemal A, Bray F. Global Cancer Statistics 2020: GLOBOCAN Estimates of Incidence and Mortality Worldwide for 36 Cancers in 185 Countries. CA Cancer J Clin. 2021;71:209-249. [RCA] [PubMed] [DOI] [Full Text] [Cited by in Crossref: 76817] [Cited by in RCA: 70120] [Article Influence: 14024.0] [Reference Citation Analysis (58)] |
| 2. | Massano J, Regateiro FS, Januário G, Ferreira A. Oral squamous cell carcinoma: review of prognostic and predictive factors. Oral Surg Oral Med Oral Pathol Oral Radiol Endod. 2006;102:67-76. [RCA] [PubMed] [DOI] [Full Text] [Cited by in Crossref: 454] [Cited by in RCA: 412] [Article Influence: 20.6] [Reference Citation Analysis (0)] |
| 3. | Warnakulasuriya S. Oral potentially malignant disorders: A comprehensive review on clinical aspects and management. Oral Oncol. 2020;102:104550. [RCA] [PubMed] [DOI] [Full Text] [Cited by in Crossref: 266] [Cited by in RCA: 209] [Article Influence: 34.8] [Reference Citation Analysis (0)] |
| 4. | Iocca O, Sollecito TP, Alawi F, Weinstein GS, Newman JG, De Virgilio A, Di Maio P, Spriano G, Pardiñas López S, Shanti RM. Potentially malignant disorders of the oral cavity and oral dysplasia: A systematic review and meta-analysis of malignant transformation rate by subtype. Head Neck. 2020;42:539-555. [RCA] [PubMed] [DOI] [Full Text] [Cited by in Crossref: 436] [Cited by in RCA: 352] [Article Influence: 58.7] [Reference Citation Analysis (0)] |
| 5. | Kayalvizhi EB, Lakshman VL, Sitra G, Yoga S, Kanmani R, Megalai N. Oral leukoplakia: A review and its update. J Med Radiol Pathol Surg. 2016;2:18-22. [DOI] [Full Text] |
| 6. | Aggarwal N, Bhateja S. “Leukoplakia- Potentially Malignant Disorder of Oral Cavity -a Review”. J Sci Tech Res. 2018;4. [DOI] [Full Text] |
| 7. | Rivera C, Venegas B. Histological and molecular aspects of oral squamous cell carcinoma (Review). Oncol Lett. 2014;8:7-11. [RCA] [PubMed] [DOI] [Full Text] [Full Text (PDF)] [Cited by in Crossref: 205] [Cited by in RCA: 168] [Article Influence: 14.0] [Reference Citation Analysis (0)] |
| 8. | Ling Z, Cheng B, Tao X. Epithelial-to-mesenchymal transition in oral squamous cell carcinoma: Challenges and opportunities. Int J Cancer. 2021;148:1548-1561. [RCA] [PubMed] [DOI] [Full Text] [Cited by in Crossref: 188] [Cited by in RCA: 158] [Article Influence: 31.6] [Reference Citation Analysis (0)] |
| 9. | Nowak E, Bednarek I. Aspects of the Epigenetic Regulation of EMT Related to Cancer Metastasis. Cells. 2021;10:3435. [RCA] [PubMed] [DOI] [Full Text] [Full Text (PDF)] [Cited by in Crossref: 87] [Cited by in RCA: 78] [Article Influence: 15.6] [Reference Citation Analysis (0)] |
| 10. | Tian X, Liu Z, Niu B, Zhang J, Tan TK, Lee SR, Zhao Y, Harris DC, Zheng G. E-cadherin/β-catenin complex and the epithelial barrier. J Biomed Biotechnol. 2011;2011:567305. [RCA] [PubMed] [DOI] [Full Text] [Full Text (PDF)] [Cited by in Crossref: 246] [Cited by in RCA: 351] [Article Influence: 23.4] [Reference Citation Analysis (0)] |
| 11. | Wong SHM, Fang CM, Chuah LH, Leong CO, Ngai SC. E-cadherin: Its dysregulation in carcinogenesis and clinical implications. Crit Rev Oncol Hematol. 2018;121:11-22. [RCA] [PubMed] [DOI] [Full Text] [Cited by in Crossref: 327] [Cited by in RCA: 292] [Article Influence: 36.5] [Reference Citation Analysis (3)] |
| 12. | Zhang P, Sun Y, Ma L. ZEB1: at the crossroads of epithelial-mesenchymal transition, metastasis and therapy resistance. Cell Cycle. 2015;14:481-487. [RCA] [PubMed] [DOI] [Full Text] [Full Text (PDF)] [Cited by in Crossref: 513] [Cited by in RCA: 498] [Article Influence: 45.3] [Reference Citation Analysis (6)] |
| 13. | Spaderna S, Schmalhofer O, Wahlbuhl M, Dimmler A, Bauer K, Sultan A, Hlubek F, Jung A, Strand D, Eger A, Kirchner T, Behrens J, Brabletz T. The transcriptional repressor ZEB1 promotes metastasis and loss of cell polarity in cancer. Cancer Res. 2008;68:537-544. [RCA] [PubMed] [DOI] [Full Text] [Cited by in Crossref: 435] [Cited by in RCA: 408] [Article Influence: 22.7] [Reference Citation Analysis (3)] |
| 14. | Zhang T, Guo L, Creighton CJ, Lu Q, Gibbons DL, Yi ES, Deng B, Molina JR, Sun Z, Yang P, Yang Y. A genetic cell context-dependent role for ZEB1 in lung cancer. Nat Commun. 2016;7:12231. [RCA] [PubMed] [DOI] [Full Text] [Full Text (PDF)] [Cited by in Crossref: 57] [Cited by in RCA: 59] [Article Influence: 5.9] [Reference Citation Analysis (0)] |
| 15. | Tian L, Guo N, Zhang N, Miao Z, Guo X, Peng N, Zhang R, Miao Y. Association of ZEB1 and FOXO3a protein with invasion/metastasis of non-small cell lung cancer. Int J Clin Exp Pathol. 2017;10:11308-11316. [PubMed] |
| 16. | Yao X, Sun S, Zhou X, Zhang Q, Guo W, Zhang L. Clinicopathological significance of ZEB-1 and E-cadherin proteins in patients with oral cavity squamous cell carcinoma. Onco Targets Ther. 2017;10:781-790. [RCA] [PubMed] [DOI] [Full Text] [Cited by in Crossref: 39] [Cited by in RCA: 33] [Article Influence: 3.7] [Reference Citation Analysis (0)] |
| 17. | Chaturvedi AK, Udaltsova N, Engels EA, Katzel JA, Yanik EL, Katki HA, Lingen MW, Silverberg MJ. Oral Leukoplakia and Risk of Progression to Oral Cancer: A Population-Based Cohort Study. J Natl Cancer Inst. 2020;112:1047-1054. [RCA] [PubMed] [DOI] [Full Text] [Full Text (PDF)] [Cited by in Crossref: 155] [Cited by in RCA: 136] [Article Influence: 22.7] [Reference Citation Analysis (0)] |
| 18. | Phulari RGS, Dave EJ. A systematic review on the mechanisms of malignant transformation of oral submucous fibrosis. Eur J Cancer Prev. 2020;29:470-473. [RCA] [PubMed] [DOI] [Full Text] [Cited by in Crossref: 32] [Cited by in RCA: 23] [Article Influence: 3.8] [Reference Citation Analysis (0)] |
| 19. | Kase S, Sugio K, Yamazaki K, Okamoto T, Yano T, Sugimachi K. Expression of E-cadherin and beta-catenin in human non-small cell lung cancer and the clinical significance. Clin Cancer Res. 2000;6:4789-4796. [PubMed] |
| 20. | Stewart DJ. Wnt signaling pathway in non-small cell lung cancer. J Natl Cancer Inst. 2014;106:djt356. [PubMed] [DOI] [Full Text] |
| 21. | Wu Y, Zhou BP. New insights of epithelial-mesenchymal transition in cancer metastasis. Acta Biochim Biophys Sin (Shanghai). 2008;40:643-650. [RCA] [PubMed] [DOI] [Full Text] [Full Text (PDF)] [Cited by in Crossref: 162] [Cited by in RCA: 169] [Article Influence: 9.4] [Reference Citation Analysis (0)] |
| 22. | Hao Y, Baker D, Ten Dijke P. TGF-β-Mediated Epithelial-Mesenchymal Transition and Cancer Metastasis. Int J Mol Sci. 2019;20:2767. [RCA] [PubMed] [DOI] [Full Text] [Full Text (PDF)] [Cited by in Crossref: 977] [Cited by in RCA: 900] [Article Influence: 128.6] [Reference Citation Analysis (6)] |
| 23. | Costa LC, Leite CF, Cardoso SV, Loyola AM, Faria PR, Souza PE, Horta MC. Expression of epithelial-mesenchymal transition markers at the invasive front of oral squamous cell carcinoma. J Appl Oral Sci. 2015;23:169-178. [RCA] [PubMed] [DOI] [Full Text] [Full Text (PDF)] [Cited by in Crossref: 59] [Cited by in RCA: 56] [Article Influence: 5.1] [Reference Citation Analysis (0)] |
| 24. | Krisanaprakornkit S, Iamaroon A. Epithelial-mesenchymal transition in oral squamous cell carcinoma. ISRN Oncol. 2012;2012:681469. [RCA] [PubMed] [DOI] [Full Text] [Full Text (PDF)] [Cited by in Crossref: 41] [Cited by in RCA: 69] [Article Influence: 4.9] [Reference Citation Analysis (0)] |
| 25. | Ghahhari NM, Babashah S. Interplay between microRNAs and WNT/β-catenin signalling pathway regulates epithelial-mesenchymal transition in cancer. Eur J Cancer. 2015;51:1638-1649. [RCA] [PubMed] [DOI] [Full Text] [Cited by in Crossref: 194] [Cited by in RCA: 200] [Article Influence: 18.2] [Reference Citation Analysis (0)] |
| 26. | Pectasides E, Rampias T, Sasaki C, Perisanidis C, Kouloulias V, Burtness B, Zaramboukas T, Rimm D, Fountzilas G, Psyrri A. Markers of epithelial to mesenchymal transition in association with survival in head and neck squamous cell carcinoma (HNSCC). PLoS One. 2014;9:e94273. [RCA] [PubMed] [DOI] [Full Text] [Full Text (PDF)] [Cited by in Crossref: 36] [Cited by in RCA: 38] [Article Influence: 3.2] [Reference Citation Analysis (0)] |
| 27. | Chaw SY, Abdul Majeed A, Dalley AJ, Chan A, Stein S, Farah CS. Epithelial to mesenchymal transition (EMT) biomarkers--E-cadherin, beta-catenin, APC and Vimentin--in oral squamous cell carcinogenesis and transformation. Oral Oncol. 2012;48:997-1006. [RCA] [PubMed] [DOI] [Full Text] [Cited by in Crossref: 240] [Cited by in RCA: 231] [Article Influence: 16.5] [Reference Citation Analysis (0)] |
| 28. | Liu W, Yao Y, Shi L, Tang G, Wu L. A novel lncRNA LOLA1 may predict malignant progression and promote migration, invasion, and EMT of oral leukoplakia via the AKT/GSK-3β pathway. J Cell Biochem. 2021;122:1302-1312. [RCA] [PubMed] [DOI] [Full Text] [Cited by in Crossref: 15] [Cited by in RCA: 15] [Article Influence: 3.0] [Reference Citation Analysis (0)] |
| 29. | van Roy F, Berx G. The cell-cell adhesion molecule E-cadherin. Cell Mol Life Sci. 2008;65:3756-3788. [RCA] [PubMed] [DOI] [Full Text] [Full Text (PDF)] [Cited by in Crossref: 1090] [Cited by in RCA: 975] [Article Influence: 54.2] [Reference Citation Analysis (8)] |
| 30. | Yuwanati MB, Tupkari JV, Avadhani A. Expression of E-cadherin in oral epithelial dysplasia and oral squamous cell carcinoma: An in vivo study. J Clin Exp Invest. 2011;2:347-353. [DOI] [Full Text] |
| 31. | Diniz-Freitas M, García-Caballero T, Antúnez-López J, Gándara-Rey JM, García-García A. Reduced E-cadherin expression is an indicator of unfavourable prognosis in oral squamous cell carcinoma. Oral Oncol. 2006;42:190-200. [RCA] [PubMed] [DOI] [Full Text] [Cited by in Crossref: 79] [Cited by in RCA: 71] [Article Influence: 3.6] [Reference Citation Analysis (0)] |
| 32. | Ren X, Wang J, Lin X, Wang X. E-cadherin expression and prognosis of head and neck squamous cell carcinoma: evidence from 19 published investigations. Onco Targets Ther. 2016;9:2447-2453. [RCA] [PubMed] [DOI] [Full Text] [Cited by in Crossref: 21] [Cited by in RCA: 23] [Article Influence: 2.3] [Reference Citation Analysis (0)] |
| 33. | Galván JA, Zlobec I, Wartenberg M, Lugli A, Gloor B, Perren A, Karamitopoulou E. Expression of E-cadherin repressors SNAIL, ZEB1 and ZEB2 by tumour and stromal cells influences tumour-budding phenotype and suggests heterogeneity of stromal cells in pancreatic cancer. Br J Cancer. 2015;112:1944-1950. [RCA] [PubMed] [DOI] [Full Text] [Full Text (PDF)] [Cited by in Crossref: 139] [Cited by in RCA: 132] [Article Influence: 12.0] [Reference Citation Analysis (4)] |
| 34. | Schmalhofer O, Brabletz S, Brabletz T. E-cadherin, beta-catenin, and ZEB1 in malignant progression of cancer. Cancer Metastasis Rev. 2009;28:151-166. [RCA] [PubMed] [DOI] [Full Text] [Cited by in Crossref: 629] [Cited by in RCA: 621] [Article Influence: 36.5] [Reference Citation Analysis (4)] |
| 35. | Ahmed S. Expression of ZEB factors in oral squamous cell carcinoma. M.Sc. Thesis, University of Louisville. 2017. Available from: https://ir.library.louisville.edu/etd/2726/. |
| 36. | Llorens MC, Lorenzatti G, Cavallo NL, Vaglienti MV, Perrone AP, Carenbauer AL, Darling DS, Cabanillas AM. Phosphorylation Regulates Functions of ZEB1 Transcription Factor. J Cell Physiol. 2016;231:2205-2217. [RCA] [PubMed] [DOI] [Full Text] [Full Text (PDF)] [Cited by in Crossref: 44] [Cited by in RCA: 37] [Article Influence: 3.7] [Reference Citation Analysis (0)] |
| 37. | Fu R, Han CF, Ni T, Di L, Liu LJ, Lv WC, Bi YR, Jiang N, He Y, Li HM, Wang S, Xie H, Chen BA, Wang XS, Weiss SJ, Lu T, Guo QL, Wu ZQ. A ZEB1/p53 signaling axis in stromal fibroblasts promotes mammary epithelial tumours. Nat Commun. 2019;10:3210. [RCA] [PubMed] [DOI] [Full Text] [Full Text (PDF)] [Cited by in Crossref: 55] [Cited by in RCA: 51] [Article Influence: 7.3] [Reference Citation Analysis (0)] |
| 38. | Soleymani L, Zarrabi A, Hashemi F, Hashemi F, Zabolian A, Banihashemi SM, Moghadam SS, Hushmandi K, Samarghandian S, Ashrafizadeh M, Khan H. Role of ZEB Family Members in Proliferation, Metastasis, and Chemoresistance of Prostate Cancer Cells: Revealing Signaling Networks. Curr Cancer Drug Targets. 2021;21:749-767. [RCA] [PubMed] [DOI] [Full Text] [Cited by in Crossref: 28] [Cited by in RCA: 24] [Article Influence: 4.8] [Reference Citation Analysis (0)] |
| 39. | Scott CL, Omilusik KD. ZEBs: Novel Players in Immune Cell Development and Function. Trends Immunol. 2019;40:431-446. [RCA] [PubMed] [DOI] [Full Text] [Cited by in Crossref: 131] [Cited by in RCA: 113] [Article Influence: 16.1] [Reference Citation Analysis (0)] |
| 40. | Karlsson MC, Gonzalez SF, Welin J, Fuxe J. Epithelial-mesenchymal transition in cancer metastasis through the lymphatic system. Mol Oncol. 2017;11:781-791. [RCA] [PubMed] [DOI] [Full Text] [Full Text (PDF)] [Cited by in Crossref: 125] [Cited by in RCA: 110] [Article Influence: 12.2] [Reference Citation Analysis (4)] |
Open Access: This article is an open-access article that was selected by an in-house editor and fully peer-reviewed by external reviewers. It is distributed in accordance with the Creative Commons Attribution NonCommercial (CC BY-NC 4.0) license, which permits others to distribute, remix, adapt, build upon this work non-commercially, and license their derivative works on different terms, provided the original work is properly cited and the use is non-commercial. See: https://creativecommons.org/Licenses/by-nc/4.0/